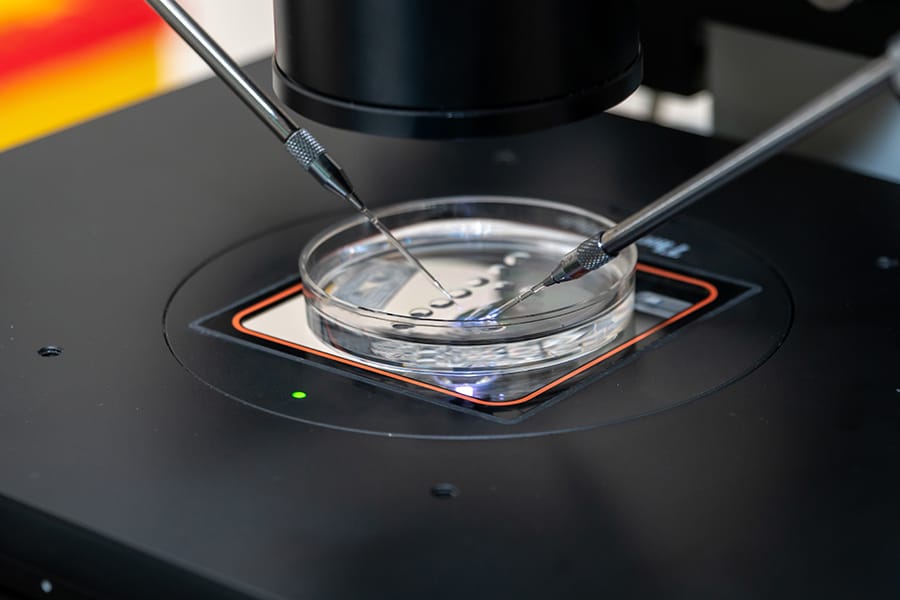

Faktor yang menurut ahli bisa meningkatkan keberhasilan program bayi tabung di antaranya adalah usia yang masih di bawah 35 tahun, asupan nutrisi, kesehatan sperma, hingga metode transfer embrio yang tepat. Kualitas sel telur dan sperma yang sehat bisa meningkatkan peluang wanita berhasil hamil dengan IVF.
Dalam dunia medis reproduksi, prosedur bayi tabung telah menjadi jalan yang penting bagi pasangan yang mengalami kesulitan dalam memiliki anak secara alami. Namun, keberhasilan dari prosedur ini tidak hanya bergantung oleh teknologi yang digunakan, tetapi juga dipengaruhi oleh sejumlah faktor lainnya. Kira-kira apa saja? Yuk, simak artikel ini sampai selesai ya.
Faktor yang Mendukung Keberhasilan Bayi Tabung
Fertilisasi In Vitro (IVF) atau bayi tabung adalah metode untuk membantu kehamilan, tempat sperma bertemu sel telur dan mengalami pembuahan di luar tubuh. Sel telur matang terambil dari ovarium dan dipertemukan secara manual dengan sperma di laboratorium untuk pembuahan.
Setelah pembuahan, sel telur yang telah terbuahi (embrio) akan pindah ke rahim. Biasanya, pemindahan pada hari kelima setelah pembuahan terjadi.
Jika embrio berhasil menempel pada dinding rahim artinya terjadi kehamilan. Meski ada kemungkinan gagal, program bayi tabung tetap bisa berhasil.
Apa saja faktor penentu yang meningkatkan keberhasilan bayi tabung? Berikut tips agar program bayi tabung yang dapat sukses:
1. Usia
Usia wanita memiliki pengaruh besar terhadap keberhasilan bayi tabung. Secara umum, kesuburan wanita menurun seiring bertambahnya usia karena kualitas telur cenderung menurun. Wanita yang lebih muda, khususnya di bawah 35 tahun, memiliki peluang keberhasilan yang lebih tinggi dalam program bayi tabung karena memiliki jumlah telur yang lebih banyak dengan kualitas yang lebih baik.
Sebaliknya, wanita di atas usia 35 tahun atau bahkan lebih tua cenderung mengalami penurunan kesuburan yang dapat memengaruhi keberhasilan program bayi tabung. Oleh karena itu, penting bagi pasangan yang ingin menjalani bayi tabung untuk mempertimbangkan usia sebagai faktor utama dalam perencanaan dan pengambilan keputusan.
Baca Juga: 9 Syarat Mengikuti Program Bayi Tabung agar Berhasil
2. Teknik Transfer Embrio
Transfer embrio merupakan langkah penting dalam prosedur bayi tabung di mana embrio berkualitas dipindahkan ke rahim wanita untuk selanjutnya berkembang menjadi janin yang sehat. Embrio berkualitas tinggi memiliki jumlah sel yang tepat, struktur yang baik, dan tingkat fragmentasi yang rendah.
Bukan hanya kualitas, teknik transfer embrio juga berperan penting. Penggunaan teknik yang tepat dan kemampuan dokter dalam menempatkan embrio dengan presisi dapat meningkatkan keberhasilan bayi tabung.
Kualitas sel telur berperan penting untuk menentukan keberhasilan program bayi tabung.
3. Riwayat Kehamilan Sebelumnya
Wanita yang pernah hamil dengan program bayi tabung bisa berpeluang sukses di program selanjutnya. Hal ini mungkin karena tubuhnya telah memiliki sistem reproduksi yang responsif terhadap teknik tersebut. Pernah berhasil dalam program bayi tabung juga dapat mengindikasikan bahwa kualitas telur baik atau lingkungan rahim yang mendukung pembuahan.
Sebaliknya, wanita yang memiliki riwayat kegagalan kehamilan atau keguguran mungkin memerlukan pendekatan lebih hati-hati dan strategis dalam program bayi tabung. Dokter dapat menyesuaikan pendekatan perawatan berdasarkan riwayat kehamilan sebelumnya untuk meningkatkan peluang keberhasilan.
4. Infertilitas atau Kesuburan
Infertilitas bisa karena berbagai masalah, termasuk gangguan hormonal, masalah struktural di dalam sistem reproduksi, kualitas sperma, atau imunologi. Setiap penyebab infertilitas ini memerlukan pendekatan yang berbeda dalam perawatan.
Misalnya, dalam kasus endometriosis atau polikistik ovarium, perlu intervensi medis tertentu sebelum prosedur bayi tabung. Memahami akar masalah kesuburan akan memungkinkan tim medis merancang strategi perawatan paling efektif dan sesuai untuk meningkatkan peluang keberhasilan bayi tabung.
Selain itu, manajemen kondisi infertilitas secara menyeluruh juga dapat meningkatkan kesejahteraan pasangan yang sedang menjalani proses ini secara emosional dan fisik.
5. Gaya Hidup
Gaya hidup yang sehat memainkan peran penting untuk meningkatkan keberhasilan program bayi tabung. Konsumsi makanan yang kaya akan nutrisi seperti sayuran, buah-buahan, protein sehat, dan biji-bijian utuh dapat meningkatkan kesehatan reproduksi baik pada pria maupun wanita.
Selain itu, menghindari kebiasaan merokok dan konsumsi alkohol yang berlebihan sangat penting karena kedua faktor tersebut dapat merusak kualitas sperma pada pria dan mengganggu siklus menstruasi serta kualitas telur pada wanita. Selain itu, menjaga berat badan ideal dan rutin berolahraga juga dapat membantu mengoptimalkan kesuburan.
Baca Juga: Mengenal Risiko Program Bayi Tabung untuk Kesehatan Ibu Hamil dan Bayi
6. Kualitas Telur dan Embrio
Wanita dengan kualitas telur yang baik memiliki peluang lebih tinggi untuk menghasilkan embrio berkualitas yang dapat meningkatkan peluang keberhasilan bayi tabung. Untuk meningkatkan kualitas telur, beberapa faktor yang perlu diperhatikan adalah asupan nutrisi yang tepat, pengurangan stres, dan penghindaran paparan zat-zat berbahaya.
Selain itu, perawatan tambahan seperti akupunktur atau suplemen tertentu juga dapat membantu meningkatkan kualitas telur. Sedangkan untuk embrio, teknologi reproduksi assisten seperti tes genetik preimplantasi (PGT-A) untuk memilih embrio paling berkualitas sebelum transfer.
7. Kualitas Sperma
Kualitas sperma memiliki dampak yang signifikan dalam kesuksesan program bayi tabung untuk menghasilkan embrio berkualitas tinggi. Beberapa cara yang bisa untuk meningkatkan kualitas sperma termasuk perubahan gaya hidup yang sehat, penghindaran faktor risiko seperti merokok dan alkohol, serta penggunaan suplemen atau terapi tertentu yang direkomendasikan oleh dokter.
8. Protokol Stimulasi Ovarium Terkendali
Protokol stimulasi ovarium terkendali adalah tahap persiapan yang penting dalam program bayi tabung. Proses ini melibatkan penggunaan obat kesuburan untuk merangsang ovarium agar menghasilkan lebih banyak sel telur matang. Pemilihan protokol stimulasi yang tepat sangat penting karena akan memengaruhi jumlah dan kualitas telur.
Dokter akan menyesuaikan protokol ini berdasarkan karakteristik dan respons tubuh pasien terhadap pengobatan yang membutuhkan pemantauan cermat selama prosesnya. Kesesuaian protokol stimulasi ini juga akan berdampak pada kemungkinan keberhasilan program bayi tabung.
9. Rumah Sakit yang Dituju
Pemilihan rumah sakit yang tepat memiliki dampak besar pada keberhasilan program bayi tabung. Rumah sakit yang memiliki fasilitas dan teknologi terkini dalam bidang reproduksi, serta staf medis yang berpengalaman, akan memberikan kesempatan yang lebih baik untuk keberhasilan prosedur tersebut.
Oleh sebab itu, melakukan riset dan konsultasi dengan beberapa rumah sakit yang memiliki reputasi baik dalam bidang reproduksi dapat membantu pasangan menentukan pilihan terbaik yang sesuai dengan kebutuhan dan harapan mereka.
Berapa Persen Kemungkinan Berhasil Hamil Bayi Tabung?
Tingkat keberhasilan program bayi tabung secara global adalah 35%. Peluang untuk hamil dengan bayi tabung jauh lebih tinggi jika wanita berusia dibawah 35 tahun dan menurun ketika berusia di atas 40 tahun.
Bagi mereka yang berusia di bawah 35 tahun dan menggunakan sel telurnya sendiri, angka kelahiran hidup adalah sekitar 46%. Sedangkan, bagi mereka yang berusia diatas 40 tahun dan menggunakan sel telurnya sendiri, angka kelahiran hidupnya adalah sekitar 22%.
Selain itu, tingkat keberhasilan program bayi tabung pertama akan berbeda dengan tingkat keberhasilan program bayi tabung kedua dan seterusnya. Jadi, penting untuk melakukan konsultasi terlebih dahulu dengan dokter agar benar-benar mengetahui peluang keberhasilannya.
Baca juga: Persiapan Sebelum Mengikuti Program Bayi Tabung
Itulah beberapa tips agar program bayi tabung berhasil. Jika Anda termasuk pasangan yang sulit hamil dan ingin melakukan program bayi tabung bisa berkonsultasi di Ciputra IVF terdekat. Ciputra IVF telah terbukti sebagai salah satu pusat pilihan terkemuka dalam penanganan masalah infertilitas dan program bayi tabung. Dengan mengunjungi Ciputra IVF, Anda dan pasangan akan mendapatkan akses kepada tim medis yang terampil dan berpengalaman dalam bidang kesehatan reproduksi.
Ciputra IVF menawarkan berbagai macam keunggulan termasuk layanan kesehatan yang lengkap. Mulai dari tahap awal konsultasi bayi tabung dengan dokter kandungan hingga proses IVF, dan tes kesuburan. Ini memastikan bahwa Anda dan pasangan mendapatkan perawatan yang sesuai dengan kebutuhan masing-masing.
Telah direview oleh Dr Sony Prabowo, MARS
Source:
- Medline Plus. In vitro fertilization (IVF). Diakses Maret 2024
- Esco Medicals. Factors Affecting IVF Success Rates. Diakses Maret 2024









